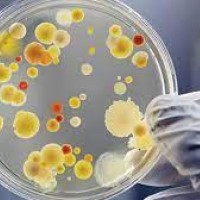
Oceanography

Top Ten Best Areas of Science
Top Ten Best Areas of Science: 35 items ranked by popular vote. Browse more in Subjects.
📊 35 items
🗳️ 0 votes
🔀 0 remixes
#1
0

Physics
#2
0

Biology
#3
0

Astronomy
#4
0

Chemistry
#5
0

Psychology
#6
0

Geology
#7
0

Computer Science
#8
0

Zoology
#9
0

Paleontology
#10
0

Quantum
#11
0

Forensic Science
#12
0

Astrophysics
#13
0

Anatomy/Physiology
#14
0
Mathematics
#15
0
Relativity
#16
0

Meteorology
#17
0

Technology
#18
0

Ecology
#19
0
Nuclear Physics
#20
0
Economics
#21
0
Electromagnetism
#22
0
Human Biology
#23
0
Redstonology (Minecraft)
#24
0

Marine Biology
#25
0

Neurology
#26
0
Social Science
#27
0
Philosophy
#28
0
Cosmology
#29
0
Oceanography
#30
0

Microbiology
#31
0

Botany
#32
0
Paleobotany
#33
0

Biochemistry
#34
0
Cartography
#35
0
Hydrology
📋 Embed this ranking on your site
+ Suggest an Item
Think something's missing? Add it to the list.
Think something's missing? Add it to the list.